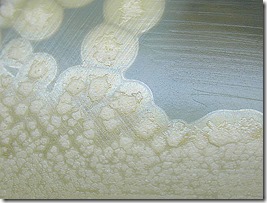
super-toxina

O novo tipo de toxina botulínica é tão mortal que seus detalhes foram retirados das bases de dados públicas.
A proteína botulínica é produzida pela bactéria Clostridium Botulinum e ela é capaz de bloquear a libertação de um produto químico que faz os músculos funcionarem.
A toxina recém-descoberta é tão devastadoramente eficaz que leva apenas dois bilionésimos de um grama para matar um ser humano adulto.
Cientistas que trabalham na pesquisa tem negado sequenciar seu DNA devido a temores de segurança. Mesmo em uma pequena quantidade da substância, as coisas poderiam acabar em um desastre e não há atualmente nenhum antídoto conhecido.
Enquanto a pesquisa sobre a toxina será publicada, as sequências genéticas específicas da substância não serão.
Um dilema semelhante aconteceu no ano passado, quando as pesquisas sobre a gripe aviária H5N1, transmissível entre mamíferos, foi publicado em meio a medo e protestos sobre segurança.